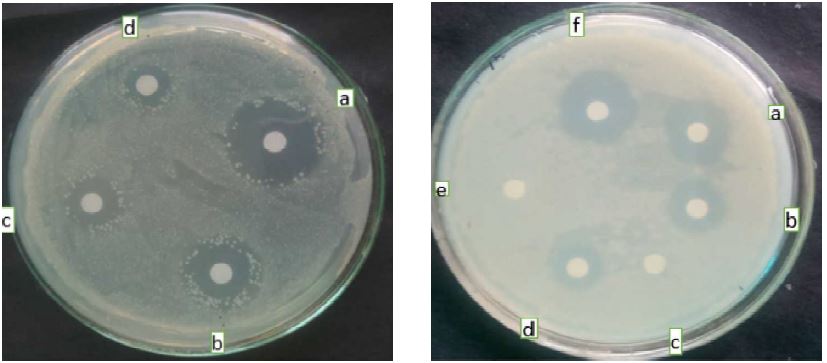
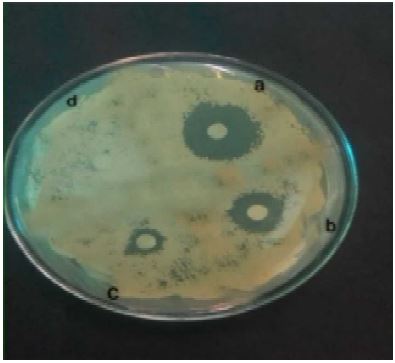

Abstract: Citrus rinds contain essential oils. One of the major constituents of the essential oils in the zest of different fruits like Citrus sinensis, C. limon, and Vitis vinifera is limonene. In this research, limonene was extracted by hydro-distillation method using Clevenger set up and its antimicrobial activity against certain bacterial and fungal strains was determined by using Kirby Bauer’s disc diffusion method. The primary antimicrobial screening of limonene without dilution exhibited a zone of inhibition (mm) comparable to Ampicillin (20mg/ml) and Amphotericin B (20mg/ml). The effect of pure limonene against all strains used was high as compared to the isolated samples. The MIC values also showed an expected decrease in the zone of inhibition from 1:2 to 1:8 dilutions. Based on this study, the cost-effective isolation of limonene and other essential oils is quite possible.
Keywords: Anti-microbial citrus, hydro-distillation and limonene.
Original Research Papers
Limonene extraction from the zest of Citrus sinensis, Citrus limon, Vitis vinifera and evaluation of its antimicrobial activity
Society for Promotion of Horticulture

Esta obra está bajo una Licencia Creative Commons Atribución-NoComercial-CompartirIgual 4.0 Internacional.
Recepción: 16 Enero 2021
Revisado: 06 Julio 2021
Aprobación: 05 Octubre 2021
Citrus fruits are generally cultivated throughout the world. A substantial load of waste is produced after their processing. An estimated amount of Citrus mash (CM) generated in South Korea was reported to be more than sixty thousand tons. Not only the edible part but also the citrus peels are well known for their phytochemical, polyphenolic, vitamin, and essential oil contents (Mahato et al., 2017). One of the major components of citrus waste is the limonene. In citrus, the outer skin known as zest contains the majority of the Limonene, whereas, traces of limonene can be isolated from the inner white kernel. Limonene is a colourless cyclic monoterpene with chemical formula C10H16 having 1-methyl-4(prop-1-en-2-yl) cyclohex- 1-ene as its IUPAC name and commonly used in food and pharmaceutical industries (Atti-Santos et al., 2005). It derives its name from the lemon as it can be derived from lemon peel. Limonene in its two optical forms is not only found in the citrus fruits but is known to exist in about 300 plant essential oils (Bacanli et al., 2015). This ten carbon compound is known to be volatile in nature and is also prone to oxidation. This oxidation generally occurs at the time of extraction and packaging. Limonene has found a wide range of applications as a flavoring and fragrance agent in many products, such as perfumes, beverages, detergents and soaps (Erasto and Viljoen, 2008). Besides this, limonene is well known for its insecticidal properties as it can penetrate the insect body through the respiratory system (fumigation), the cuticle (contact effect), or the digestive system (ingestion effect)(Prates et al., 1998) .
Limonene has a characteristic citrus odor and is colorless with a molar mass of 136.24g/mol. Since it has a chiral center with four functional groups around so, it exists in two isomeric forms I, e d-limonene and l- limonene. The d-limonene is common in lime, lemon, orange, tangerine, etc. It has a density of about 84kg/ m3 which is lesser than the water I, e 997kg/m3 (Erasto and Viljoen, 2008).
The presence of this 10 carbon compound is also attributed to various plant genera like Lippia (frog fruit) and Artemisia (Mugwort, Sagewort). This optically active compound is generally found in its d- form. However, l-form is also found in Pinus and Menthespecies. Limonene has been found to exhibit herbicide and antifeedant properties and acts as an attractant for pollinators. This compound with its two isoprene units has tremendous antioxidant properties as it saturates the pulmonary membrane and gives protection against endogenous and exogenous oxidant agents like ozone (Erasto and Viljoen, 2008). Limonene can generally be extracted by various methods like steam distillation, cold press, solvent extraction, and hydro-distillation using the Clevenger system.
The emergence of drug resistant bacterial and fungal species poses a serious global public health concern. Hence, it is imperative to search for novel compounds to contain these pathogens. In this regard phytochemicals can be very useful. Hence, in this study antibacterial and antifungal properties of limonene extracted from Citrus sinensis, C. limon, and Vitis vinifera were evaluated.
The samples of the known variety of C. sinensis, C. limon, and V. viniferawere collected from the local street vendor in the commonly used polythene bag. The samples were washed initially with tap water and then with distilled water to make the outer surface sterilized (Shaw et al., 1997).
The fresh orange (1000g), Lemon (500g), and grape (500g) after surface sterilization were gently pressed against the grater to remove the zest without removing any part of the white flesh. The peel of V. vinifera was obtained manually. Then the peels of V. vinifera and zest of C. sinensis and C. limon were transferred to round bottom flasks (RBF). After that water was added into the RBF along with porcelain chips to prevent splashing of the zest and peels to the neck and allow smooth boiling (Gelb et al., 1995; Malko and Wróblewska, 2016). The distillation process was proceeded at a temperature of 70°C. The distillate was collected after one and a half hours and then continuing the process again. The distillate was left undisturbed for about 20 minutes and then removed carefully using a pipette.
The crude essential oil rich in limonene isolated from zest of Citrus sinensis, Citrus limon, and Vitis vinifera were detected by comparing the odour of the pure limonene with that of the isolated samples. Furthermore, the detection of crude limonene was performed by comparing the pH with that of pure limonene (Lopez-sanchez and Pagliaro, 2014). For the detection of the crude limonene from the zest of C. sinensis (OIL), C. limon (LIL), and V. vinifera (GIL) biochemical assays such as Iodine test and Bromine test as described by Wang and Weller, 2006, and Asbahani et al., 2015, respectively.
The strains which include gram-positive (B.subtilis, M.luteus, and S. aureus), gram-negative (E.coli, K.pneumoniae, A.hydrophila, and P.pituda), and fungal (C. albicans, C. parapsilosis and S.cerevisiae) were obtained from microbial type culture collection (MTCC) (Lucchesi et al., 2004). All the bacterial and fungal cultures were initially revived in the nutrient broth and yeast extract peptone dextrose (YEPD) broth, respectively and growth was checked as per the method described by Bhattacharya et al., (2014).
After the revival of microbes the antimicrobial activity of the crude essential oils rich in limonene was determined by using Kirby Bauer’s disc diffusion method (Akhtar et al., 2017a; Akhtar et al., 2017b; Choudhury et al., 2017). In brief the microbes were grown overnight at 37°C and 28°C in Nutrient broth and YEPD broth for bacterial and fungal species respectively. Then 100 µl of the culture were spread on Nutrient agar and YEPD agar plates. Then, sterile filter discs containing different concentration of the essential oils rich in limonene extracted from zest of C. sinensis, C. limon and V. vinifera were placed on the plates. The plates were further incubated at 37°C for bacterial species and 28°C for fungal species. After the incubation, the zone of inhibition was measured. Ampicillin was used as control for bacterial species and Amphotericin B was used as control for fungal species.
Distillate obtained after Hydro-distillation is given in the table 1. The pH of the crude essential oils was almost the same as that of pure limonene. The color change during the biochemical assays such as Iodine test and Bromine water test also confirmed the presence of limonene in the crude essential oils (Figure 1 and Figure 2). The limonene content in orange zest, limonene zest, and grape peels were 2.0 mL, 2.7mL and 3.46mL for every 100 g of samples respectively.
Distillate obtained after Hydrodistillation

The maximum anti-microbial activity was shown by the pure limonene (97%) for all the tested strains. Among the ten strains, the maximum effect of pure limonene was found in the case of B. subtilis with a zone of inhibition (ZOI) measuring about 12mm. The minimum effect was revealed against C. albicans with ZOI measuring about 3mm (Karr, 1989). On comparing the results of three crude essential oil isolates the maximum effect was shown by the OIL and LIL against K. pneumoniae (7mm) and S. aureus (8mm) respectively. The crude essential oil rich limonene isolated from the grape peels showed good positive effects against E.coli (0.7mm) and B. subtilis (0.5mm) while it showed ZOI in the range of 1mm- 3mm against all other strains (Figure 3, 4, 5) (Bhattacharya et al., 2014) . However, GOl, was found to be ineffective against all the fungal strains. So, pure limonene showed the maximum anti- microbial activity in comparison to the three isolates, whereas, the OIL and LIL showed maximum effect against gram positive bacteria than those of gram negative bacteria. The effects shown by the limonene are given below (Table 2):

Figure 1
The antimicrobial activity of (i) pure limonene (PL), (ii) crude essential oil isolated from C. limon (LIL), against E. coli at different concentration- (a). 1:2 (b). 1:4 (c). 1:6 (d). 1:8

Figure 2
Antifungal activity of essential oils against C. parapsilosis (a). PL (b). OIL (c). LIL (d) GIL
Antimicrobial activity of essential oils against different bacteria and fungi

All those bacteria showing a zone of inhibition equal to 4mm or more were tested for determining the microbiostatic/microbicidal of a particular type of limonene. On the other hand, those with ZOI below 4mm were not tested (-). There was a continuous decrease in the ZOI of inhibition from less diluted sample to a more diluted sample (Figure 4 and 5). Besides the continuous decline in the ZOI, there were some unusual results shown by the P.putida for 1:2 and 1:4 LIL. Similar uncommon results were shown by E. coli and B. subtilis (Bold letters). Similar type of findings were reported in previous studies against
E. coli, P. putida, and S. aureus (Akhtar et al., 2017a, 2017b; Bilal Ahmad et al., 2020). C. parapsilosis and S. cerevisae showing ZOI equal to 4mm or more for OIL and PL respectively were tested using different dilutions of these two samples. C. albicans was not tested because it did show susceptibility without dilution. There was a continuous decrease in the ZOI from less diluted sample to more diluted samples. The summary of microbiostatic/microbiocidal effect of crude essential oils rich in limonene with different dilutions is given in Table 3.
MicrobiostaticMicrobicidal effect of limonene with different dilutions

In the study crude essential oil rich in limonene were extracted from Citrus sinensis, Citrus limon, and Vitis vinifera by hydro-distillation with Clevenger set-up. The detection of limonene in these crude essential oils were confirmed by different biochemical assays. The isolated crude essential oil rich in limonene showed potential antimicrobial activity against different Gram-positive and Gram- negative bacteria as well as also three fungal species. This study shows that the limonene rich essential oils of C. sinensis, C. limon and V. vinifera has the potential to be used in drug and food industry to control various pathogens.
Conflict of interest: The authors declare no conflict of interest.
Distillate obtained after Hydrodistillation

Figure 1
The antimicrobial activity of (i) pure limonene (PL), (ii) crude essential oil isolated from C. limon (LIL), against E. coli at different concentration- (a). 1:2 (b). 1:4 (c). 1:6 (d). 1:8
Figure 2
Antifungal activity of essential oils against C. parapsilosis (a). PL (b). OIL (c). LIL (d) GIL
Antimicrobial activity of essential oils against different bacteria and fungi

MicrobiostaticMicrobicidal effect of limonene with different dilutions

